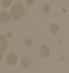

Jenis BBM

Pada Tahun 2024
Pertamax Green 92 (Menggantikan Pertalite)
Pertamax Green 95
Pertamax Turbo

Jenis BBM

Pada Tahun 2024
Pertamax Green 92 (Menggantikan Pertalite)
Pertamax Green 95
Pertamax Turbo
Pertamina akan mulai menghapus
Pertalite tahun depan. Hal itu diumumkan oleh
Direktur Utama PT Pertamina (Persero) Nicke Widyawati, dalam Rapat Dengar Pendapat (RDP) bersama Komisi VII DPR, kemarin.
BOGORPolusi udara yang buruk di Jabodetabek belakangan ini berdampak pada kesehatan warga. RSUD
Kota Bogor mencatat terjadi 30 persen kasus Infeksi Saluran Pernafasan Akut (ISPA).
Hal itu diungkapkan Kepala Bidang Pelayanan Medik RSUD Kota Bogor,
Tahun 2022
Januari 54
TOKYO–’’Ini sangat enak.’’ Perdana Menteri (PM) Jepang Fumio Kishida melontarkan pujian tersebut ketika menyantap sashimi bersama tiga menteri di jajaran kabinetnya kemarin (30/8).
JAKARTA–Ekosistem di perguruan tinggi betul-betul direformasi oleh Menteri Pendidikan, Kebudayaan, Riset, dan Kebudayaan (Mendikbudristek) Nadiem Makarim. Tak hanya mengubah standar kompetensi kelulusan, ia juga mengganti standar proses pembelajaran dan penilaian mata kuliah. Dalam standar proses pembelajaran, Nadiem mengubah aturan mengenai Satuan Kredit Semester (SKS). Jika sebelumnya, beban belajar bagi mahasiswa per satu SKS sama dengan 50 jam pembelajaran per minggu, ditambah pula penugasan terstruktur 60 menit per minggu hingga kegiatan mandiri selama 60 menit per minggu. Maka, kini semua dipangkas.
Kita harus mengatur berapa lama di ruang kelas, berapa lama jam waktu PR, kegiatan mandiri berapa. Ini sudah tidak relevan lagi,” Mendikbudristek Nadiem Makarim
PROTES: Warga Korea Selatan melakukan aksi unjuk rasa sebagai bentuk protes kepada pemerintah Jepang yang membuang air limbah Fukushima

NANTI sore ada debat penting: Debat

IKN. Di Teater Kecil Taman Ismail Marzuki, Jakarta. Yang menyelenggarakan: Akademi Jakarta. Yakni, sebuah badan yang tugasnya, antara lain, mengangkat pengurus Dewan Kesenian Jakarta.
dr Andy Prianto. Dia mengatakan tren kasus ISPA mengalami kenaikan diakibatkan polusi udara yang melewati angka ambang batas.
Februari 57 Maret 32
April 18
Mei 20
Juni 33
Juli 40
Agustus 81
September 67
Oktober 72
November 44
Desember 65
Tahun 2023
Januari 84
Data Kasus ISPA RSUD Kota Bogor
Rafael Alun Didakwa Pidana Pencucian Uang Rp100 Miliar

Mantan pejabat Direktorat Jenderal Pajak (DJP), Kementerian Keuangan (Kemenkeu) Rafael Alun Trisambodo menjalani sidang perdana, kemarin (30/8). Ayah Mario Dandy Satriyo tersebut didakwa menerima gratifikasi dan tindak pidana pencucian uang (TPPU). Dua perbuatan itu dilakukan bersama-sama dengan istri Rafael, Ernie Meike Torondek.
SIDANG PERDANA: Mantan pejabat Ditjen Pajak Kementerian Keuangan Rafael Alun Trisambodo mengikuti sidang dakwaan dugaan penerimaan gratifikasi dan tindak pidana pencucian uang (TPPU) di Pengadilan Tipikor Jakarta, Rabu (30/8/).
DALAM surat dakwaan yang dibacakan jaksa penuntut umum (JPU) KPK, Rafael dan istrinya didakwa bersama-sama menerima gratifikasi sebesar Rp16,6 miliar. Gratifikasi yang berasal dari puluhan wajib pajak itu diterima Rafael melalui tiga perusahaan jasa milik istrinya. Yakni, PT Artha Mega Ekadhana (PT ARME), PT Cubes Consulting, dan PT Bukit Hijau Asri.
JAKARTA–Tingkat belanja memasuki pertengahan kuartal III 2023 masih menunjukkan resiliensi.
Hingga 13 Agustus 2023, Mandiri Spending Index (MSI) mencatatkan angka 164,4.
Meski melemah dari bulan sebelumnya, belanja masyarakat itu lebih tinggi 64,4 persen dibandingkan periode sebelum pandemi.
Secara bulanan, nilai belanja masyarakat pada Juli 2023 mencatatkan angka 168,1. Meningkat 31,8 persen dibandingkan bulan yang sama tahun lalu sebesar 127,5.
Berdasar wilayah, belanja di Kali-
mantan, Maluku-Papua, Sumatera, dan Bali-Nusa Tenggara mencatatkan percepatan belanja bulan ini.
Sedangkan perlambatan belanja terjadi di Jawa dan Sulawesi.
’’Dalam hal komposisi belanja, seluruh kategori belanja hingga pertengahan Agustus ini mengalami normalisasi, kecuali elektronik dan perlengkapan rumah tangga yang terus meningkat,” kata Chief Economist Bank Mandiri Andry Asmoro, Kamis (24/8). Secara bulanan, belanja terkait dengan perlengkapan rumah tangga per Juli mencapai level 117.6. Indeks
tersebut tumbuh sekitar 10,01 secara tahunan.
Pertumbuhan solid dalam belanja perlengkapan rumah tangga terjadi sejak Mei 2023. Artinya, masyarakat menunjukkan optimisme konsumen yang kuat.
Secara kelompok pendapatan, belanja masyarakat bawah atau saldo tabungan di bawah Rp1 juta terus meningkat.
Hingga 13 Agustus, MSI dari kelompok ini mencapai 196,8. Sementara itu, masyarakat menengah dengan saldo tabungan Rp1 juta–Rp10 juta relatif stabil dan berada di kisaran
185,7.
’’Secara umum kenaikan belanja masyarakat kelompok bawah lebih

BOGOR–PT Olympic Bangun Persada bekerjasama dengan PT Marga Sarana Jabar membangun gerbang tol Bogor Outer Ring Road (BORR) di dalam kawasan One Central Business District (OCBD). Ini tentu menambah alternatif akses baru di wilayah Kota Bogor.
Direktur Utama PT Marga Sarana
Jabar Dedi Krisnariawan Sunoto mengatakan adanya fasilitas akses langsung tersebut memberikan kemudahan bagi mobilitas masyarakat sekitar yang hendak menuju Tol BORR maupun sebaliknya, tanpa harus melewati kepadatan, yang biasanya terjadi di Jalan KS Tubun dan Jalan Raya Bogor pada jam-jam sibuk.
“Kami berharap ribuan kendaraan bisa bangkit di sini. Sehingga juga dapat mengurangi beban arus lalu
lintas di Tol Jagorawi,” ucap Dedi, usai peletakan batu pertama pembangunan akses jalan tol ke kawasan OCBD, Jumat (25/8).
Dedi menjelaskan PT Marga Sarana Jabar tahun depan akan melanjutkan proyek Tol BORR seksi 3B. Jalan bebas hambatan ini kelak akan terhubung salah satunya dengan jalan Tol Depok-Antasari.
“Ruas ini nanti sangat strategis. Ini nanti kan bisa ke Antasari, Serpong, dan (rencana) bisa terhubung ke IPB Dramaga, Cianjur, Puncak, lalu Karawang,” beber dia.
Wali Kota Bogor Bima Arya mengatakan, keberadaan gerbang tol di kawasan OCBD diharapkan dapat memacu pengembangan wilayah dan pemerataan pembangunan di Kota Bogor.
“Ini memang bagian desain besar Pemkot Bogor, untuk mengintegrasikan Jakarta dan sekitarnya. Kami berharap perkantoran banyak bergeser kesini (OCBD). Sehingga mengurangi beban di pusat kota,” ucap Bima.
Jalan Tol Bogor Outer Ring Road (BORR) seksi IIB dari Kedung Badak ke Yasmin sepanjang ruas 2,65 kilometer.
Sementara itu, CEO PT Olympic Bangun Persada, Norman Edward Sebastian, mengatakan gerbang tol dari OCBD menuju Tol BORR ditargetkan rampung akhir tahun 2023. Ruas tol ini terintegrasi dengan Tol Jagorawi dan Sentul.
“Sesuai arahan Pak Wali Kota, Desember tahun ini selesai dibangun. Untuk DED (detail engineering design) sudah selesai,” ujarnya.
PT. Olympic Bangun Persada sebagai salah satu property developer di bawah naungan Olympic Group saat ini tengah mengembangkan kawasan hunian yang terintegrasi dengan area komersial, bisnis dan gaya hidup. Kawasan OCBD merupakan area seluas 25 hektar, tepat berada di tengah Kota Bogor.
Norman berharap pembangunan konstruksi akses langsung dari kawasan OCBD menuju tol BORR ini dapat memberikan kontribusi positif tidak hanya bagi penghuni di kawasan OCBD, namun juga aksesibilitas dan mobilitas masyarakat sekitar. “Dengan begitu diharapkan mampu menggerakkan perekonomian dan meningkatkan kualitas hidup warga masyarakat di Kota Bogor,” pungkas dia. (mer/c)
JAKARTA–CNBC Indonesia menggelar Indonesia Tech Conference 2023 dengan tema “Collaboration for Innovation” pada Selasa, 22 Agustus 2023 di Samasara Grand Ballroom, Sopo Del Tower.
Acara ini menjadi momentum pertemuan para founder startup, pelaku bisnis, dan pemangku kepentingan dari berbagai sektor industri.
Menteri Kesehatan Budi Gunadi Sadikin pun hadir untuk memberikan keynote speech. Selain itu, hadir pula Direktur Utama Peruri Dwina
Septiani Wijaya dan Direktur Group
Business Development Telkom



Indonesia Honesti Basyir.
Acara ini merupakan forum diskusi untuk mendorong startup Indonesia menjadi unicorn. Oleh karenanya diperlukan kolaborasi dengan stakeholders dari pemerintahan.
Peruri dihadirkan dalam acara ini sebagai salah satu perusahaan yang telah berhasil menjalankan transformasi digital dan membagikan kiat-kiat sukses perjalanan transformasi bisnisnya. Badan Usaha Milik Negara (BUMN) yang bertugas mencetak uang dan
DIGITALISASI: Setelah merambah digital, Peruri mengklaim mengalami penambahan customer.
dokumen berharga lainnya ini tercatat telah melakukan transformasi digital, setidaknya sejak lima tahun terakhir. Dwina menjelaskan, proses transformasi digital di Peruri ditandai dengan era pembayaran nontunai. Sebelumnya, Kata Dwina, Peruri belum memiliki bisnis di bidang digital.
“Bagaimana kita dalam lima tahun ini melayani beberapa customer produk digital. Sebelumnya Peruri kan bisnis penugasan, ada dari Bank Indonesia, Ditjen Pajak, Ditjen Bea Cukai, Ditjen Imigrasi dan BPN. Tapi saat Peruri masuk era digital, kami memiliki lebih dari 700 customer baru,” ungkap Dwina. Dwina memaparkan transformasi digital yang dilakukan Peruri bukan semata untuk bertahan dan mengikuti perkembangan zaman. Dia menjelaskan setelah masuk ke era digital, fokus bisnis Peruri mengalami pergeseran. Di mana Peruri mulai menawarkan solusi mengenai produk penjaminan keaslian dan autentikasi. Menurutnya, transformasi ini dilakukan dengan memanfaatkan bisnis yang belum dimiliki. (jp)
Kolaborasi E-Commerce dengan Pelaku Digital
banyak ditopang oleh tabungan mereka. Data menunjukkan bahwa indeks DPK (dana pihak ketiga)
dari kelompok bawah terus menurun, namun belanja mereka terus meningkat,” bebernya. (jp)

JAKARTA–Pemerintah Arab Saudi terus menggencarkan program
Vision 2030. Salah satu agendanya adalah meningkatkan jumlah kunjungan jemaah umrah. Arab Saudi menargetkan jumlah kunjungan umrah bisa mencapai 15 juta kunjungan tiap tahunnya.
Target besar Arab Saudi itu membuka peluang bisnis bagi para pelaku usaha travel atau penyelenggara perjalanan ibadah umrah (PPIU). Khususnya bagi travel umrah yang ada di Indonesia. Pasalnya jumlah jamaah umrah dari Indonesia selalu menduduki papan atas setiap tahunnya.
Sejumlah travel umrah resmi di Indonesia menyambut peluang besar itu. Diantaranya disampaikan oleh Managing Director Gaido Travel Achmad Faiz. Menurut dia peluang bisnis di usaha travel umrah dan haji khusus masih terbuka lebar. Meskipun secara regulasi, Arab Saudi sudah memberikan lampu hijau penjualan paket umrah secara langsung ke jamaah atau masyarakat.
Faiz menuturkan bagi sebagian masyarakat, mendirikan usaha travel umrah dari awal bisa jadi rumit. Pasalnya persyaratan yang ditentukan oleh pemerintah Indonesia sangat banyak. Termasuk harus berangkat dari travel wisata umum terlebih dahulu.
Untuk mengatasi kendala tersebut, masyarakat bisa mencoba usaha travel umrah secara waralaba atau franchise. Dia mencontohkan Gaido membuka layanan waralaba travel umrah dengan modal awal Rp150 juta.
“Masyarakat sudah bisa memulai bisnis haji umrah tanpa harus berkutat dengan berbagai proses perizinan yang rumit dan panjang,”
katanya di sela mengikuti pameran License and Business Concept Expo and Conference (IFRA) 2023 di Tangerang pada Jumat (25/8).
Dia menjelaskan menjalankan bisnis umrah terikat dengan ekosistem pelayanan yang luas. Seperti layanan pembiayaan untuk bisa berangkat umrah. Kemudian juga layanan kesehatan haji dan umrah. Termasuk juga layanan promosi kepada masyarakat. Di bagian lain, tingginya animo masyarakat yang ingin menjalankan umrah, tidak hanya membutuhkan layanan travel atau biro perjalanan. Tetapi juga keberadaan Kelompok Bimbingan Ibadah Haji dan Umrah (KBIHU). Kementerian Agama (Kemenag) kembali mengingatkan ada beberapa syarat penting dalam pendirian KBIHU.
Direktur Bina Haji Ditjen Penyelenggaraan Haji dan Umrah (PHU) Kemenag Arsyad Hidayat mengatakan, jika ingin mendirikan KBIHU ada beberapa persyaratan yang ha rus dipenuhi sesuai dengan Peratu ran Menteri Agama (PMA) Nomor 7 tahun 2023. “Adapun per sya ratan yang dipenuhi yaitu satu, memiliki legalitas pembentukan KBIHU,” katanya.
Syarat kedua adalah KBIHU harus memiliki kantor dan tempat bimbingan. Ketiga KBIHU memiliki pembimbing ibadah yang tetap dan bersertifikat yang masih berlaku minimal satu orang.
Kemudian syarat yang keempat adalah KBIHU memiliki lembaga pendidikan, pondok pesantren, atau majelis taklim. Syarat yang terakhir adalah, KBIHU wajib mempunyai silabus manasik Ibadah Haji dan umrah.(jp)
Di tengah kemajuan era digital, kolaborasi semakin menunjukkan kekuatan peran dalam mendukung perkembangan yang menghasilkan berbagai inovasi.
HAL ITU menjadi salah satu latar belakang hadirnya Shopee Connect yang ditujukan untuk para konten kreator, mitra brand & penjual. Acara tersebut turut dimeriahkan Abel
Cantika (Content Creator & Shopee Affiliate), Monica Vionna (Head of Marketing Growth Shopee Indonesia), serta mitra brand yang turut mendukung Ms Glow, Cool-Vita, Unilever Indonesia, BOLDe, naPocut dan

Wardah. Sebagai bagian dari kemeriahan kampanye 9.9 Super Shopping Day, Shopee Connect mengangkat pembahasan mengenai pentingnya kolaborasi dan sinergi dari seluruh pihak untuk bersama-sama meningkatkan daya saing dan peluang perkembangan bisnis dalam diskusi panel bertemakan ‘Unleash Your Potential Through Impactful Collaborative Networking’ Head of Marketing Growth Shopee Indonesia Monica Vionna mengatakan, sebagai platform e-commerce, Shopee menjadi perpanjangan tangan antara penjual, pembeli, serta mitra brand untuk bertumbuh. Melihat antusiasme pengguna serta dampak positif dari program yang dihadirkan,
Shopee ingin memperkuat potensi kolaborasi yang lebih baik lagi bagi seluruh ekosistem. Baik itu konten kreator, mitra brand, serta penjual melalui acara Shopee Connect.
Di tengah era modern, masyarakat dikelilingi oleh berbagai kemudahan dan peluang yang dilahirkan oleh kemajuan teknologi. Dengan pesatnya perkembangan tersebut, adaptasi dan usaha untuk terus meningkatkan daya saing merupakan langkah penting untuk bertahan. Melihat pentingnya sinergi dan peran seluruh pihak, Shopee berharap ruang diskusi dan koneksi dapat menunjang perjalanan konten kreator, mitra brand serta penjual dalam memanfaatkan fitur Shopee. “Khususnya Shopee Affiliate Program dan Shopee Live.
Sehingga tidak hanya meningkatkan potensi diri, tapi juga dapat mendukung kolaborasi antara konten kreator dengan mitra brand dan penjual untuk mengoptimalkan fitur yang dihadirkan guna mendapatkan peluang dan keuntungan lebih besar melalui konten-konten kreatif dan inspiratif,” ujar Monica Vionna.
Menjadi wadah bagi banyak pelaku usaha serta mitra brand untuk perkembangan bisnis, dan di saat yang sama menjadi solusi bagi pengguna untuk memenuhi berbagai kebutuhan, program yang dihadirkan seperti Shopee Affiliate Program dan fitur Shopee Live menjadi bukti nyata dalam menawarkan peluang serta dampak positif bagi seluruh ekosistem Shopee.(*jp)


Sampaikan unek-unek
(021)87972380, 081296019016


Rumah Sakit Salak (0251) 8344609/834-5222
RSUD Ciawi (0251) 8240797
Klinik Utama Geriatri Wijayakusuma (0251) 7568397
Rumah Sakit Bina Husada (021) 875-8441
Rumah Sakit ibu dan anak Nuraida(0251) 8368107, (0251) 368866
Yayasan Bina Husada Cibinong (021) 875-8440
Rumah Sakit Bersalin Assalam Cibinong (021) 875-3724
Rumah Sakit Bersalin Tunas Jaya Cibinong (021) 875-2396
Rumah sakit Bina Husada Cibinong (021) 8790-3000
Rumah sakit Ibu dan Anak Trimitra Cibinong (021) 8756-3055
Rumah Bersalin & Klinik Insani Cibinong (021) 875-7567
RS Sentosa Bogor, Kemang (0251)-7541900
RS Ibu dan Anak Juliana, Bogor (0251) 8339593, Fax. (0251)-8339591
RSIA Bunda Suryatni (0251) 7543891,(0251) 754-3892
Klinik Insani Citeureup (021) 879-42723
RSIA Kenari Graha Medika Cileungsi (021) 8230426
Rs Paru Dr. M. Goenawan Partowidigdo
Cisarua-Bogor (0251) 8253630, 8257663
RS Asysyifaa Leuwiliang (0251) 8641142
RS Vania IGD (0251) 8380613, (0251) 8380601/8380605
RSKIA Sawojajar (0251) 8324371

CANTUMKAN IDENTITAS LENGKAP
PUSAT Pelaporan dan Analisis Transaksi Keuangan (PPATK) mencatat penyebaran uang melalui transaksi judi online meningkat tajam. Pada 2021 nilainya mencapai Rp57 triliun dan naik signifikan pada 2022 menjadi Rp81 triliun.
Kepala Biro Humas PPATK Natsir Kongah mengatakan hal tersebutsangatmengkhawatirkan. Apalagi, masyarakat yang ikut judi online tidak hanya orang dewasa, tetapi ada anak kecil yang masih Sekolah Dasar (SD).
”Nah ini sesuatu yang meng-
BARUBARU ini Indonesian Corruption Watch (ICW) menemukan setidaknya 15 mantan terpidana korupsi dalam Daftar Calon Sementara (DCS) bakal calon legislatif (bacaleg) yang diumumkan oleh Komisi Pemilihan Umum (KPU) pada 19 Agustus 2023.
Bacaleg mantan terpidana kasus korupsi itu mencalonkan diri untuk pemilihan umum (pemilu) 2024 di tingkat Dewan Perwakilan Rakyat (DPR), Dewan Perwakilan Rakyat Daerah (DPRD) dan Dewan Perwakilan Daerah (DPD). Mereka berasal dari berbagai partai politik (26/08/2023).
Menurut peneliti ICW, Kurnia Ramadhana membuktikan bahwa partai politik masih memberi karpet merah kepada mantan terpidana korupsi. Pencalonan mantan napi korupsi sempat ada larangan dari KPU, hanya saja dengan alasan HAM pada tahun 2018 MA membatalkan larangan tersebut.
Kebolehan mantan napi menjadi bacaleg ini, di satu sisi seolah tak ada lagi rakyat yang pantas mengemban amanah. Di sisi lain menunjukan adanya kekuatan modal yang dimiliki oleh bacaleg tersebut, mengingat untuk menjadi caleg saat ini membutuhkan biaya yang sangat besar.
Timbul kekhawatiran di tengah-tengah masyarakat akan resiko terjadinya korupsi kembali, apabila bacaleg ini lolos dalam kontestasi. Terlebih hukum saat ini tidak memberikan efek jera kepada pelaku kejahatan termasuk korupsi.
Ummu Naziha, Cianjur
gelisahkan untuk kita semua karena memang orang-orang yang terlibat di judi online ini banyak ibu rumah tangga, rakyat miskin, bahkan anak SD pun ada yang ikut terlibat di judi online, ini yang kita khawatirkan,” ujarnya dalam diskusi Polemik Trijaya
FM, Sabtu (26/8-2023). Kondisi ini akibat cerminan buruknya dari penerapan sistem ekonomi kapitalis yang gagal mensejahterakan rakyat, dan gagalnya sistem pendidikan mencetak generasi berkepribadian islam. Walaupun Kominfo
sudah melakukan pemblokiran 5000 situs judi online namun tidak cukup karena pelaku penyedia permainan sangat banyak dan harus lah negara yang bisa menutupnya Yoyoh H, Gunung Putri
JUDI sudah dikenal sejak zaman dulu. Seiring perkembangan ilmu pengetahuan dan teknologi judi mengalami perkembangan. Judi kini tidak hanya di laku kan secara konvensional lagi tapi juga secara online, yang lebih dikenal dengan judi online.
Meski namanya sedikit berbeda dengan menambahkan kata online, tapi pada dasarnya sama. Judi online dilakukan dengan cara taruhan uang atau barang berharga.
Judi online dapat dilakukan dimana saja asalkan memiliki kuota data. Bahkan, judi online telah masuk pada kalangan anak-anak. Bagaimana tidak, anak-anak adalah salah satu kalangan yang dekat dengan internet.

Rasa keingintahuan mereka masih sangat besar sehingga mempelajari hal baru bukanlah sesuatu yang sulit
bagi mereka. Padahal seperti yang telah diketahui, permainan yang bersifat online seringkali menimbulkan efek negatif baik itu secara fisik, psikologis. Apalagi pada permainan judi online yang jelas sangat bertentangan dengan norma agama. Potensi efek kecanduan yang akan dirasakan oleh anak yang bermain judi online tentu akan sulit dibendung tatkala kontrol orangtua, sekolah bahkan negara tidak ketat.
Anak-anak yang bermain judi online akan mengalami gangguan fokus dalam belajar, mengantuk ketika jam belajar, menyendiri atau bahkan melakukan segala cara demi mendapatkan uang untuk bermain judi online.
Padahal, anak-anak adalah generasi penerus bangsa yang seharusnya menggunakan potensinya dalam hal positif untuk membangun bangsa
dan negara. Oleh karena itu, mau tidak mau diakui, bahwa keimanan dan ketakwaan pada Allah swt menjadi pondasi utama seorang anak dalam menolak pengaruh judi online. Dengan ketaqwaan yang tinggi seorang anak tidak hanya akan berpkir bagaimana memajukan diri sendiri tapi juga negaranya. Tidak hanya itu, kontrol dari masyarakat pun dibutuhkan agar pilar penjaga semakin kokoh.
Terakhir, perang negara dalam membendung perjudian baik itu yang dilakukan secara konvensional dan on line dibutuhkan karena efek buruknya tidak hanya bersifat individual saja tapi juga dalamjangka panjang akan berpengaruh buruk pada kemajuan bangsa dan negara.
Riri RikeuAnda terhadap layanan publik seperti PLN, PDAM, PT Pos, telepon, jalan rusak, pungli, kemacetan, pembuatan KK/KTP/SIM/ paspor/ sertifikat tanah, dll.
Cantumkan nama dan alamat lengkap, nomor telepon yang bisa dihubungi, nomor pelanggan (untuk layanan PDAM/PLN/PT Gas) dan lampirkan fotokopi KTP. Kirimkan ke Redaksi Radar Bogor, Gedung

JONGGOL Bencana kekeringan di Kabupaten Bogor meluas. BPBD Kabupaten Bogor mencatat, sudah ada 27 kecamatan di Kabupaten Bogor terdampak kekeringan.
”Sementara hingga hari ini ada


174.770 warga Bogor yang meminta bantuan air bersih, tersebar di 95 desa,” kata Kasi Kedaruratan
Kabupaten Bogor. Sementara itu Camat Jonggol Andri Rahman mengatakan, jumlah desa yang alami kekeringan di wilayahnya juga bertambah. Saat ini sudah ada sembilan desa yang alami krisis air bersih.
MENGERING: Areal sawah yang terdapat di wilayah Jonggol, Kabupaten Bogor, mulai pecahpecah dan kering tanahnya.







FOTO ARIFAL/RADAR BOGOR





SEKRETARIS Daerah (Sekda) Kabupaten Bogor, Burhanudin minta kepada para Kepala Perangkat Daerah (PD) dan Camat se-Kabupaten Bogor untuk sinergi gerak cepat menangani bencana alam kekeringan yang melanda sejumlah wilayah di Kabupaten Bogor, hal itu ditegaskan Sekda Kabupaten Bogor saat memimpin apel di halaman kantor Setda, Rabu (30/8).
Ia juga meminta kepala PD dan Camat untuk juga sosialisasikan kepada masyarakat kekeringan ini diprediksi akan berlangsung hingga September kita akan memasuki musim penghujan pada Oktober nanti.
“Kita harus gerak cepat antisipasi secara bersamasama agar bisa lebih maksimal dalam penanganannya, karena kemarau ini tidak hanya kekeringan juga potensi kebakaran dan penyakit disentri kolera, gagal panen dan lainnya,” ungkap Burhan.
Lanjut Sekda, Pemkab Bogor secara rutin terus mengirimkan pasokan air bersih untuk masyarakat yang terdampak kekeringan, sekitar 18 tangki air bersih diturunkan untuk mendistribusikan air bersih secara bergantian ke wilayah yang mengalami kekeringan dan kesulitan pasokan air bersih.
“Ada 18 Tangki air bersih kita kirim secara bergantian ke 98 desa setiap harinya, walau belum maksimal harapan kami minimal kebutuhan masyarakat terpenuhi,” jelas Sekda.
“Para kepala PD akan kami “kawinkan” dengan 40 camat untuk melakukan intervensi stunting di kecamatan masing-masing. Tiap camat akan didampingi satu kepala PD dan pejabat utama yang ditugaskan menangani stunting melalui Surat Keputusan Bupati, supaya Kabupaten Bogor bebas stunting 2024,” imbuh dia). (*pia)
BPBD Kabupaten Bogor, M Adam kepada Radar Bogor, Rabu (30/8). Adam memaparkan, permintaan air bersih merata, kini hampir di sejumlah wilayah yang ada di Kabupaten Bogor meng alami kesulitan air bersih. Baik itu di wilayah Timur, Barat, dan Utara
paten (Pemkab) Bogor membangun sumur bor di 17 kecamatan, dipersoalkan Kades Gunung Putri, Daman Huri. Menurut Kades Daman Huri, sebelum membangun sumur bor, seharusnya Pemkab Bogor berkaca pada Desa Gunung Putri. “Pembuatan sumur bor tidak efektif bagi penanggulangan kekeringan di Bogor,” ujar Daman Huri.
Hal itu, terlihat dari sumur bor yang dibangun di Desa Gunung Putri. Memasuki musim kemarau, sumur bor di sana tidak berfungsi. Alias kering. ”Sumur-sumur bor bantuan pemerintah desa, baik dana pemerintah maupun swasta pun banyak yang kering tidak beroperasi,” kata Daman Huri kepada Radar Bogor, Rabu (30/8). Memang, kata Daman Huri,
pembangunan sumur bor itu dilakukan untuk menanggulangi krisis air bersih yang terjadi di Kabupaten Bogor. Namun, kenyataannya masih belum bisa mengatasi permasalahan kekeringan di Desa Gunung Putri. Daman mengatakan, di desanya itu ada delapan sumur bor yang dibangun dari bantuan pemerintah desa, baik dana pemerintah maupun swasta. Sumur bor tersebut tersebar di sebelas RW yang ada di Desa Gunung putri. “Dari delapan, hanya tiga yang masih bisa beroperasi,” tutur dia. Untuk itu, iapun meminta agar pemerintah melalui PDAM Tirta Kahuripan bisa melayani warga Desa Gunung Putri yang alami kekeringan. Karena dengan masuknya PDAM, tentunya tidak akan terjadi krisis air di Desa Gunung Putri, Kecamatan Gunung Putri.
“Kekeringan ini setiap tahun, dengan masuknya PDAM, bisa jadi solusi jangka panjang,” tukas dia. Sementara itu, Asisten Manager Layanan Pelanggan Perumda Tirta Kahuripan Agus Wahid, mengungkapkan saat kegiatan Obsesi di Graha Pena Radar Bogor, beberapa waktu lalu, jika penyambungan pipa Tirta Kahuripan belum bisa dilakukan di semua wilayah Kabupaten Bogor. “ Selain lokasi yang tidak memungkinkan, kontur dan medan wilayahnya juga belum bisa dimasuki jaringan pipa PDAM,” ungkap Agus.
Ada beberapa kantor wilayah Perumda Tirta Kahuripan, kata Agus, yang mempunyai aliran air siap tampung di tangki mobil BPBD.
“Sehingga bagi warga yang membutuhkan bisa berkordinasi dengan pemdesnya dan menghubungi BPBD, maka kami siap mendistribusikan
”Iya terus bertambah,” tutur Andri. Untuk penanganan jangka panjang, Andri memaparkan, akan dibangun embung di sejumlah desa yang ada di Jonggol.
”Nanti direncanakan dibangun embung di beberapa desa,” tutur dia. Adapun untuk jumlah penduduk di Kecamatan Jonggol Yeng terdampak kekeringan sudah mencapai 4.000 jiwa.
Bahkan, irigasi di sebagian wilayah Jonggol juga mulai mengering. Seperti diungkapkan Enah, warga lansia di Desa Sukasirna, Jonggol. Ia mengaku mengunakan dasar aliran sungai irigasi itu untuk menyeberangi Jalan Raya Jonggol menuju salah satu sumber air yang tersisa.
Ya, sudah hampir satu bulan, saluran irigasi di Desa Sukasirna, Kecamatan Jonggol, Kabupaten Bogor kering. Tak ada air mengalir di saluran irigasi selebar empat meter itu. Hujan tak kunjung turun di wilayah Timur Kabupaten Bogor itu. ”Tiap hari, gak usah nyeberang di atas (jalan raya),” ungkap dia, kepada Radar Bogor, Rabu (30/8).

Ia menceritakan, tinggal di dekat saluran irigasi belum menjamin terbebas dari krisis air. Hampir setiap tahun wilayah tempat bermukimnya itu kekeringan. Tahun ini, menjadi yang paling parah. “Tahun 2019, itu juga sampai kering. Tahun 2021 dan 2022 air masih ada walau hanya sedikit, tahun ini kering lagi,” tutur dia.
Sementara itu, Kasi Kedaruratan BPBD kabupaten Bogor, M Adam Hamdani mengatakan, kekeringan dan krisis air meluas di Jonggol. Hingga saat ini tercatat ada 10 desa yang meminta bantuan pengiriman air bersih ke BPBD Kabupaten Bogor. “Jonggol ini salah satu daerah paling banyak terdampak,” tukas dia. (all/c)
SAMA-SAMA

KERING: Tampak salah satu Sumur Bor yang dibangun di Desa Gunung Putri. Dari sepuluh sumur, hanya tiga yang berfungsi.

air bersih ke wilayah yang mengalami kekeringan,” tandas dia. Sebelumnya, Sekda Kabupaten Bogor Burhanudin mengungkapkan, untuk mengatasi kekeringan dalam jangka panjang Pemkab Bogor akan membangun sumur bor tambahan di 17 kecamatan. “Sumur
bor akan dibangun di 17 kecamatan oleh PUPR Kabupaten Bogor dengan rincian sebagai berikut, 13 sumur bor dibangun menggunakan anggaran APBD Kabupaten Bogor dan 4 sumur bor dibangun menggunakan anggaran APBN,” tukas Burhanudin. (all/c)
NEYMAR











RIYADH–Aleksandar Mitrovic resmi berkostum
Al Hilal SC pada 19 Agustus lalu atau empat hari setelah deal Neymar Jr dengan klub Saudi
Pro League tersebut.




















Tetapi, ketika Mitrovic telah melakoni dua laga, termasuk dalam kemenangan 2-0 atas
Al Ettifaq FC pada pekan keempat SPL, Selasa (29/8), Neymar masih belum bermain.



Sejauh ini, kehadiran Neymar belum
”dibutuhkan” . Sebab, dalam dua laga bersama

Mitrovic, Al Hilal selalu menang dan nirbobol.
Mitrovic juga berkontribusi masing-masing
1 gol dan 1 umpan gol.
Selain Mitrovic, Al Hilal memiliki Malcom
maupun bintang lokal pencetak gol ke gawang
Argentina dalam Piala Dunia 2022 Salem Al
Dawsari.
”Ketika tiba (di Al Hilal, Red), dia (Neymar, Red) dalam keadaan cedera. Ada sedikit masalah
di ototnya. Aku belum tahu pasti kapan dia
akan main,” ungkap pelatih Al Hilal Jorge Jesus seperti dilansir ESPN.
Dua hari lalu, Neymar sejatinya telah menjalani debut latihan bersama Al Hilal.
Hanya, pemain dengan nilai transfer termahal dunia itu tidak melahap semua materi latihan dan masih didampingi oleh tim medis klub.
Sangat mungkin mantan bintang
FC Barcelona dan Paris Saint-Germain
itu belum tersedia dalam Saudi El
Clasico kontra juara bertahan SPL Al Ittihad Club pada pekan kelima akhir pekan nanti (2/9).
Artinya, sangat mungkin
Neymar baru debut pada pekan keenam
kontra Al Riyadh SC (16/9) alias setelah agenda internasional.(jpc)





BIRMINGHAM– Prediksi Aston Villa vs Hibernian leg 2 playoff UEFA Europa Conference League (UECL) 2023/2024
mengunggulkan tim tuan rumah yang memimpin 0-5 di leg pertama. Laga akan berlangsung di Stadion Villa Park, Birmingham, Jumat (1/9) dini hari (live Streaming pukul 02.00 WIB).

Aston Villa hampir dapat dipastikan lolos ke babak penyisihan grup UECL 2023/2024.
Pasalnya, dengan keunggulan 0-5 di Stadion Eeaster Road, tim asuhan Unai Emery hanya akan tersingkir jika bisa kebobolan 6 gol.
Andai The Villans kalah 0-4 atau 1-5 sekalipun, mereka tetap bisa menyingkirkan Hibernian yang merupakan wakil Skotlandia. Sementara itu, Hibernian butuh keajaiban untuk mem-
balikkan situasi.
Misi Aston Villa untuk kembali tampil di kompetisi Eropa sejak terakhir di UEFA Cup (sekarang Liga Europa) 2008/2009 kian mendekati kenyataan. The Villans bisa tetap lolos sekalipun takluk dengan skor 0-4. Situasi unggul 5 gol berpotensi dimanfaatkan Aston Villa untuk mengendurkan otot. Pasalnya, tak lebih dari 3 hari usai laga lawan Hibernian, Villa akan menjalani duel berat menghadapi Liverpool pada lanjutan pekan 4 Liga Inggris 2023/2024. Kendati begitu, kekalahan nampaknya tak akan menjadi opsi utama bagi Moussa Diaby dan kolega. Sang pelatih, Unai Emery tentu tetap ingin memberi kegembiraan bagi fans, seperti yang ia lakukan di laga terakhir saat menaklukan Burnley 1-3. Di sisi lain, laga kontra Hibernian jadi kesempatan Emery untuk meningkatkan performa tim. “Kami berbagi tiga poin (lawan Burnley) itu dengan pendukung kami dan berusaha membuat semua orang bersemangat. Akan sulit dan minggu depan melawan Liverpool,” kata Emery usai laga melawan Burnley, dikutip dari laman Aston Villa. Terlepas dari jadwal padat yang telah menanti, Aston Villa secara keseluruhan telah menunjukkan performa positif. Mereka meraih 3 kemenangan beruntun dengan potensi lini serang yang kian menjanjikan. Total, 12 gol sudah mereka ciptakan hanya dalam 3 laga. “Para pemain melakukan gameplan dengan sempurna. Ini adalah tantangan yang sangat besar. Kami mencoba bermain secara taktis, bertahan dan menyerang, dengan kuat,” kata Emery yang mantan pelatih Arsenal itu. Sementara itu, situasi sulit tengah dihadapi Hibernian jelang lawatan ke Birmingham. Selain harus mengejar defisit 5 gol, mereka juga masih harus beradaptasi dengan pelatih anyar setelah pemecatatan Lee Johnson, Minggu (27/8).




Keputusan tim tak lepas dari rentetan hasil minor dalam 2 laga terakhir.
Usai dibantai Aston Villa 0-5, Hibernian kembali menderita kekalahan di Liga Skotlandia atas Livingston dengan skor 2-3. Kekalahan itu seluruhnya tercipta pada partai kandang. “Klub telah mengambil keputusan sulit untuk memecat Lee Johnson dari tugasnya menyusul awal yang mengecewakan,” tulis rilis resmi Hibernian. (trt/rur)









MANCHESTER–Manchester United menghabiskan banyak uang di awal jendela transfer, dengan lebih dari £150 juta dibayarkan untuk Mason Mount, Andre Onana, dan Rasmus Hojlund. Namun, seperti dikutip dari The Mirror, konsensus umum di kalangan penggemar dan pakar adalah bahwa penambahan lebih lanjut diperlukan jika Setan Merah ingin bersaing memperebutkan gelar musim ini.
Sayangnya, mendatangkan lebih banyak orang ke Old Trafford sebelum batas waktu hari penutupan bursa transfer Jumat ini terbukti sangat sulit. Masalah utama tim Erik ten Hag adalah ketidakmampuan mereka menjual pemain. United sejauh ini belum menghasilkan dana penjualan sebanyak yang diharapkan oleh para petinggi klub. Akibatnya, ditambah dengan pengeluaran besarbesaran mereka di awal musim panas, United beroperasi dalam batasan keuangan yang ketat karena aturan Finansial baru dari UEFA.

Sejumlah pemain dalam jajaran bintang Setan Merah saat ini tampaknya ditakdirkan untuk pergi lebih awal di jendela transfer.
Harry Maguire kehilangan tempatnya sebagai starter beberapa waktu lalu dan juga kehilangan perannya sebagai kapten klub. Namun, pemain internasional Inggris itu sekarang tampaknya akan bertahan di klub setelah musim panas ini setelah kesepakatan dengan West Ham gagal.
The Hammers telah mengajukan tawaran 30 juta untuk mengamankan tanda tangan Maguire yang dengan cepat disetujui oleh United. Kerumitan muncul ketika tiba waktunya untuk menyetujui persyaratan pribadi, dengan Maguire memilih untuk menolak minat dari pasukan David Moyes.
Scott McTominay juga menjadi incaran West Ham dan Everton, tetapi tidak ada yang benarbenar berusaha untuk merekrut pemain Skotlandia itu.
Donny van de Beek tetap berada di pinggiran tim utama United, gagal mendapatkan banyak perhatian dan juga gagal menarik banyak minat nyata di tempat lain.
Di tengah semua kesulitan dan kesuraman finansial, United mendapat kelonggaran karena fakta bahwa kiper cadangan Dean Henderson berada di ambang kepindahan senilai £15 juta ke Crystal Palace yang bisa meningkat menjadi £20 juta jika klausul tambahan diaktifkan.
Anthony Martial juga masih bisa menjadi aset bagi United dalam hal penjualan, dengan tiga klub berbeda tertarik untuk mengamankan jasa pemain Prancis itu.
Kepergian para pemain ini akan membuat klub bisa mendapatkan pemain seperti Marc Cucurella dan Sofyan Amrabat yang sudah dilaporkan siap ke Old Trafford.
LONDON–Striker Manchester City Erling Haaland memenangkan penghargaan Pemain Terbaik Liga Premier PFA. Sementara pemain sayap Arsenal Bukayo Saka dinobatkan sebagai Pemain Muda Terbaik PFA. Haaland, yang mencetak 36 gol di musim pertamanya di Liga Premier untuk membantu membawa City meraih gelar, menduduki puncak suara di depan John Stones, Kevin de Bruyne, Saka, Martin Odegaard dan Harry Kane. Haaland juga masuk dalam PFA

Premier League Team of the Year bersama rekan setimnya di City De Bruyne, Rodri, Stones, dan Ruben Dias. “Merupakan suatu kehormatan untuk memenangkan penghargaan bergengsi ini,” kata Haaland dikutip dari Metro. Bagi Haaland, ini adalah apresiasi untuk kinerjanya. “Diakui oleh kompetitor adalah perasaan yang luar biasa dan saya ingin mengucapkan terima kasih kepada semua orang yang telah memilih saya,” ujarnya.(jpc)


TIMNAS Indonesia U-17 mendapat pembelajaran berharga usai kalah tipis 0-1 dari Korea Selatan U-17 dalam laga persahabatan di Stadion Patriot Candrabhaga, Bekasi, Rabu (30/8). Kedua tim muda itu langsung menerapkan permainan pressing ketat sejak awal laga, meski tim muda Korsel sejatinya lebih dominan dalam penguasaan bola.

Tercatat, beberapa peluang sempat diperoleh Kim Myeongjun, Lee Sang-min, dan Yoon Doyong. Namun, upaya mereka gagal dikon versi menjadi gol karena rapatnya pertahanan Garuda Nusantara yang digalang Iqbal Gwijangge. Selain itu, upaya tim muda Korsel juga masih belum sepenuhnya sempurna. Fakta itu membuat
JAKARTA– Rehan Naufal
Kusharjanto mendapat perhatian khusus selama tampil di Kejuaraan Dunia 2023. Salah satunya karena berat badan. Bodi pasangan Lisa Ayu Kusumawati di sektor ganda campuran tersebut dianggap tidak proporsional.
Terkait hal itu, Rehan menceritakan, seluruh pemain di Pelatnas PBSI Cipayung setiap kali mau tampil di pertandingan pastinya menjalani timbang berat badan terlebih dahulu. ’’Di situ ada ukuran otot, lemak, dan lainnya. Ada dokter khusus juga untuk masalah berat badan,’’ ujarnya kepada Jawa Pos (Radar Bogor Group).
Karena itu, di setiap timbang berat badan tersebut, ada grafik serta perbandingan dengan yang ditimbang sebelumnya.
’’Kemarin terakhir timbang beratnya naik, lemaknya turun 2 persen, tetapi otot naik 3 persen. Sekarang berat saya 72 kg,’’ tuturnya.
Rehan melanjutkan, dirinya pernah berada pada posisi berat badan di 67–68 kg. ’’Tapi, apa yang terjadi, badan saya lemas
tidak ada tenaga. Padahal, pas di berat itu, saya sudah nge-gym terus. Tapi, tetap saja badan lemas sering kram,’’ ucapnya. Karena itulah, dia berkonsultasi dengan sang ayah yang merupakan legenda ganda campuran Indonesia, Tri Kusharjanto.
’’Setelah saya nanya ayah, katanya perut boleh buncit.
Tapi, gym-nya harus ekstra lagi,’’ ujar peraih juara Hylo Open 2022 itu.

’’Ya sudah, akhirnya saya nurutin ayah. Karena saya nggak bisa ngurangin makan, saya cuma bisa jaga makan,’’ lanjutnya.
Saat malam, Rehan mengurangi gula dan tidak nyemil.
’’Tapi, karena posisinya saya pertandingan terus, jadi agak susah mau nge-gym (secara intensif),’’ sebut pria 23 tahun itu. Disinggung berat badan ideal untuknya, Rehan memiliki jawaban pribadi.
’’Untuk saya, selagi ngerasa pas main tidak berat dan nyaman, buat saya itu sudah cukup, sih. Tapi, saya tetap melakukan penguatan dan nambahin otot lagi,’’ ujarnya.(jpc)
gawang Indonesia tetap aman dari gempuran. Sementara Indonesia U-17 sempat merespon dengan memberikan tekanan. Tercatat, Kafiatur Rizky dan Aulia Rahman sempat memberikan ancaman ke jantung pertahanan Korsel. Sayang, kurang tenang membuat upaya mereka belum membuahkan hasil.
Kedua tim pun harus rela bermain
imbang tanpa gol hingga berakhirnya babak pertama, walau intensitas jual beli serangan diperagakan kedua tim.
Memasuki babak kedua, Pelatih Bima Sakti memberikan instruksi lebih menyerang kepada para pemainnya. Strategi itu sempat terlihat ketika Risky Afrisal sempat melakukan tusukan ke daerah pertahanan Korsel, namun upaya
Risky belum cukup kuat untuk menjadi gol. Korsel akhirnya berhasil memecahkan kebuntuan ketika Baek Gaon berhasil memaksimalkan bola rebound usai Ikram Al Giffari menepis umpan Jin Taeho pada menit ke66. Gol itu membuat Korsel makin bersemangat menggempur pertahanan Indonesia. Terbukti, mereka
nyaris menggandakan kedudukan lewat penalti pada menit ke-78. Namun, Yang Seuk-un gagal mengonversi peluang itu menjadi gol setelah sepakannya membentur mistar gawang. Setelah itu, Indonesia coba keluar menekan. Indonesia sempat memiliki peluang lewat aksi Ahmad Zidan, namun sepakannya masih melebar tipis dari gawang Korsel.(jpc)
BOGOR–PSB Bogor serius dalam menatap Liga 3 Seri 1 Jawa Barat 2023. Laskar Pakuan melakukan pemusatan latihan yang berlangsung di Safin Pati Football Academy (SPFA), Kabupaten Pati, Jawa Tengah. Jawara tiga kali Piala Suratin itu akan berada di Pati antara satu hingga dua bulan. Sebanyak 24 pemain yang lolos seleksi akan mendapatkan rangkaian pelatihan, dan uji coba melawan tim-tim sekitar Jateng.

Ketua Umum PSB Bogor, Nasrul Zahar mengatakan, para pemain
SELEKSI: Persatuan Bola Voli Seluruh Indonesia (PBVSI) kembali mengerucutkan jumlah pemain Timnas Voli Indonesia jelang berlaga di ajang Asian Games 2023
JAKARTA–Persatuan Bola Voli Seluruh Indonesia (PBVSI) kembali mengerucutkan jumlah pemain
yang terpilih mengikuti training centre (TC) di Pati, akan mendapatkan pelatihan berkesinambungan di salah satu akademi sepak bola terbaik di Indonesia. “Mereka berada di Pati hingga Liga 3 Seri 1 Jabar bergulir. Sekitar Oktober mendatang,” ujarnya di sela-sela pelepasan tim di Stadion Pajajaran, Rabu (30/8). Sebenarnya, sambung dia, ada 27 pemain yang lolos seleksi. Namun, tiga berhalangan ikut ke Pati dengan berbagai alasan. “Satu pemain
mengundurkan diri. Dua lainnya tak bisa meninggalkan kuliah. Sehingga kami beri tugas untuk latihan mandiri sambil dipantau tim pelatih,” imbuhnya.
Nasrul menjelaskan, tidak menutup kemungkinan ada seleksi tambahan selama menjalani TC di Pati. Khususnya untuk pemain senior. “Ada lima pemain yang didaftarkan. Tapi kuota turun di lapangan hanya tiga. Untuk usia harus kelahiran 2001 ke bawah.”
“Para pemain senior ini dibutuhkan
untuk menambah kekuatan tim,” tambahnya.
Terkait status Isman Jasulmei sebagai pelatih PSB Bogor, Nasrul mengungkapkan dalam waktu dekat akan diresmikan. Hubungan chemistry yang terbangun sejak Juni lalu, menjadi alasan manajemen untuk mengangkatnya sebagai pelatih kepala. “Beliau yang memimpin seleksi, jadi sudah tahu kemampuan para pemain. Tinggal butuh asisten pelatih dan pelatih kiper. Nanti akan ditentukan sembari TC berjalan,” tukasnya.(rur)
Timnas Voli Indonesia jelang berlaga di ajang Asian Games 2023.
Sebelumnya melalui pengumuman di akun media sosial resmi, PBVSI mencantumkan 14 nama.
Daftar pemain tersebut sama dengan skuad yang dikirimkan ke Kejuaraan Asia pekan lalu.
Namun, setelah dua pemain diumumkan di coret dari daftra tersebut. Dan hanya menyisahkan 12 pemain saja.
Alasan hanya 12 pemain saja yang dikirim untuk berlaga di ajang Asian Games 2023 tak lepas dari aturan pada pesta olahraga Asia tersebut.
“Mengapa tidak 14 pemain yang dikirim ke Asian Games 2023? Keputusan untuk mengirimkan hanya 12 pemain bukanlah karena kita. Setiap negara peserta juga hanya mengirimkan 12 pemain, sesuai dengan regulasi yang ditetapkan oleh panitia Asian Games,” kata
Manajer Tim Voli Indonesia Loudry Maspaitella dilansir dari rilis resmi PBVSI, Rabu (30/8). Adapun untuk dua nama pemain yang dicoret adalah Cep Indra Agustin yang berposisi sebagai middle blocker dan Irpan yang bermain sebagai libero.
Deretan pemain seperti Fahri Septian, Farhan Halim, Hendra Kurniawan, dan Doni Haryono bakal berlaga di Hangzhou bulan depan.(fjr)

CIBINONG–Pemerintah Kabupaten (Pemkab) Bogor bakal melakukan roadshow ke setiap desa untuk meminimalisir konflik pada Pemilu 2024.

Sekretaris Daerah Kabupaten Bogor, Burhanudin mengatakan, ini
merupakan upaya antisipasi yang dilakukan bersama Polres Bogor dalam menciptakan kondusifitas pemilu mulai dari wilayah paling kecil.
“Kapolres punya program tentang pengamanan pemilu, untuk persiapannya dimulai dari sekarang.
Bersama Kapolres kami akan
JAKARTA–Perubahan nama Koalisi
Kebangkitan Indonesia Raya (KKIR) mengagetkan PKB. Pihak PKB mengaku tidak diajak bicara terkait perubahan nama tersebut.
KKIR yang diinisiasi PKB dan Partai
Gerindra ini berubah nama menjadi Koalisi Indonesia Maju (KIM). Nama baru koalisi itu diumumkan langsung Ketua Umum DPP Partai Gerindra
Prabowo Subianto pada perayaan

HUT Ke-25 PAN, Senin, 28 Agustus.
Kini pihak PKB mengaku tidak dilibatkan dalam perubahan nama koalisi tersebut. Parpol yang dilahirkan PBNU itu merasa tidak diajak bicara.
Ketua DPP PKB Luluk Nur Hamidah mengaku tak mengetahui tujuan dari perubahan nama koalisi. Dia tidak menampik bahwa Muhaimin tak dilibatkan dalam prosesnya. Padahal, lanjut dia, secara etika seharusnya dibicarakan lebih dulu.
Sebab, sejarah kelahiran KKIR yang jadi embrio tidak boleh dari PKB dan Gerindra.
KKIR tidak lain diambilkan dari spirit nama dua partai. Yakni, kata kebangkitan dari PKB, sedangkan
Indonesia Raya dari Gerindra yang merupakan kependekan dari Gerakan Indonesia Raya.
Sejak kerja sama itu ditandatangani,
PKB selalu memegang komitmen bersama dan tak pernah ingkar. Mengetahui ada perubahan nama tanpa melibatkan Muhaimin, wajar PKB sangat gemas. Apakah itu bagian dari upaya meminggirkan peran PKB dan nama Muhaimin sebagai bacawapres Prabowo? Luluk menyebut boleh jadi demikian. ’ “Kader PKB tentu merasa tidak nya man. Lho, kok begini?’’ ungkapnya. Namun, lanjut Luluk, hal itu bisa menjadi kesempatan bagi PKB untuk terus membuka diri terhadap berbagai kemungkinan yang bakal terjadi. Sebab, perkembangan politik sangat dinamis. Sejauh ini, Muhaimin bisa menjalin komunikasi dengan semua pihak. Baik bersama koalisi parpol pendukung Ganjar Pranowo (bacapres PDIP) maupun Anies Baswedan (bacapres Koalisi Perubahan untuk Persatuan).
Sebagaimana kerap disampaikan ulama-kiai, Luluk menegaskan bahwa PKB adalah kunci kemenangan. Sejak pemilihan umum presiden (pilpres) digelar secara langsung, kandidat yang didukung PKB selalu menang. ’’Sejarah mencatat, PKB berhasil memenangi empat kali pilpres. Semua calon yang didukung terpilih,’’ paparnya.(fjr)
melakukan roadshow ke desa-desa,” kata Burhanudin, Rabu (30/8).
Menurutnya, Pemkab Bogor memberikan pintu lebar untuk stakeholder lainnya dalam rangka melakukan koordinasi demi pengamanan pemilu.
Selain itu, Pemkab Bogor juga terbuka bagi penyelenggara pemilu
jika ingin melakukan kerja-kerja pemilu yang membutuhkan bantuan pemerintah daerah.
“Misalnya KPU mau bertemu dengan camat, Bawaslu minta keamanan, bisa koordinasi ke pemerintah daerah,” tuturnya. Sementara, Kapolres Bogor AKBP Rio Wahyu Anggoro mengaku,
pihaknya telah melakukan pemetaan terhadap wilayah di Kabupaten Bogor yang rawan konflik Pemilu 2024.

“Kami sudah lakukan pemetaan, kurang lebih ada sekitar 28 atau 29 wilayah dan itu tersebar di semua wilayah,” ungkapnya. Dengan tingginya potensi konflik
tersebut, pihaknya pun sudah berkoordinasi dengan Pemkab Bogor dan juga unsur TNI untuk sama-sama menjaga kondusifitas Pemilu 2024.
“Kami libatkan juga personel lainnya. Seperti TNI dan juga Satpol PP dari Pemkab Bogor untuk menjaga kondusifitas pemilu,” tandasnya.(cok)
DEPOK–Badan Eksekutif Mahasiswa (BEM) Universitas Indonesia sudah mengirimkan surat undangan resmi untuk bakal calon presiden (bacapres) dalam Pemilu 2024 pada Selasa (29/8).
“BEM UI resmi mengirimkan surat undangan dari mahasiswa UI untuk Ganjar Pranowo, Anies Baswedan, dan Prabowo Subianto ke alamatnya
masing-masing,” kata Ketua BEM UI Melki Sedek Huang kepada wartawan, Rabu (30/8).
Ia mengatakan bahwa debat bacapres bersama mahasiswa itu akan dilangsungkan pada 14 September mendatang di Universitas Indonesia.
“Kini kami akan menunggu konfirmasi dan kesediaan dari tiap bacapres
JAKARTA–Ketua Komisi Pemilihan Umum (KPU) RI Hasyim Asy’ari menyatakan pihaknya segera merevisi peraturan KPU (PKPU) nomor 15 Tahun 2023 tentang Kampanye Pemilu.
“Sebagai konsekuensi dari putusan MK nomor 65/PUUXXI/2023, kami akan melakukan revisi PKPU, terutama tentang larangan kampanye di tempat ibadah, kemudian dibolehkan kampanye di tempat pendidikan dan fasilitas pemerintah,” katanya di Kompleks Parlemen, Senayan, Jakarta.
Dia menyatakan revisi PKPU itu saat ini sedang dalam penyusunan draft. Selain itu, KPU harus mendiskusikan dengan berbagai pihak seperti Kementerian Pendidikan, Kementerian Agama, partai politik dan lembaga terkait. Nantinya, PKPU itu akan dikonsultasikan dengan Komisi II DPR.
KPU akan mengatur lembaga
untuk hadir dan memaparkan gagasan kebangsaannya di depan mahasiswa UI,” ucapnya.
“Kami harap ini menjadi momentum untuk kita meramu ulang masa depan bangsa. Masa depan bangsa ini harus dituntun dengan gagasangagasan dan tiap Bacapres harus jadi orang yang siap mengemukakan gagasan itu dengan paripurna di
pendidikan yang boleh dijadikan tempat kampanye pemilu hanya perguruan tinggi. Hasyim menjelaskan perguruan tinggi merupakan satu-satunya lembaga pendidikan yang seluruh civitasnya sudah mempunyai hak pilih dalam pemilu.
Ia menegaskan hal itu sesuai dengan ketentuan dalam UndangUndang (UU) tentang Pemilu, yang melarang pelibatan warga negara yang belum masuk kategori pemilih dalam acara kampanye. “Kalau di Sekolah Menengah Atas (SMA) ‘kan masih sebagian di bawah 17 tahun, dan sebagian sudah 17 ke atas,” katanya. Sebelumnya, Mahkamah Konstitusi (MK) mengabulkan sebagian per mohonan perkara
pengujian Undang-Undang Nomor
7 Tahun 2017 tentang Pemilihan Umum (UU UU Pemilu) yang diajukan oleh Handrey Mantiri, pada Selasa (15/8) di ruang sidang
pleno MK.
Para Pemohon mempersoalkan ihwal larangan kampanye menggunakan fasilitas pemerintah, tempat ibadah, dan tempat pendidikan, yang diatur dalam penjelasan
Pasal 280 ayat (1) huruf h UU
Pemilu. “Amar putusan, mengadili, mengabulkan permohonan para pemohon untuk sebagian,” kata Ketua MK Anwar Usman dengan didampingi delapan hakim konstitusi, saat mengucapkan amar Putusan Nomor 65/PUUXXI/2023.
MK dalam amar putusan tersebut juga menyatakan penjelasan Pasal 280 ayat (1) huruf h UU Pemilu sepanjang frasa ”Fasilitas pemerintah, tempat ibadah, dan tempat pendidikan dapat digunakan jika peserta pemilu hadir tanpa atribut kampanye pemilu atas undangan dari pihak penanggung jawab fasilitas pemerintah, tempat
ibadah, dan tempat pendidikan” bertentangan dengan UUD 1945 dan tidak mempunyai kekuatan hukum mengikat. Selain itu, MK menyatakan Pasal 280 ayat (1) huruf h UU Pemilu bertentangan dengan UUD 1945 dan tidak mempunyai kekuatan hukum mengikat sepanjang tidak dimaknai “mengecualikan fasilitas pemerintah dan tempat pendidikan sepanjang mendapat izin dari penanggung jawab tempat dimaksud dan hadir tanpa atribut kampanye pemilu”
Dengan demikian, maka Pasal 280 ayat (1) huruf h UU Pemilu selengkapnya berbunyi, “menggunakan fasilitas pemerintah, tempat ibadah, dan tempat pendidikan, kecuali untuk fasilitas pemerintah dan tempat pendidikan sepanjang mendapat izin dari penanggung jawab tempat dimaksud dan hadir tanpa atribut kampanye pemilu”(jpc)
kampus yang memang adalah tempat menguji juga mengulas gagasan,” tegas Melki. Sementara itu, di hari yang sama, Selasa (29/8) kemarin, Anies Baswedan justru menghampiri markas BEM UI untuk menjemput bola undangan debat tersebut. “Hari ini saya baru saja selesai memberi kuliah umum di FISIP UI,
selesai itu kemudian saya mampir ke Sekretariat BEM UI untuk merespons undangan dari BEM untuk kegiatan debat,” katanya dalam video yang diunggahnya di Instagram resmi @aniesbaswedan, Selasa (29/8).
Namun, sayangnya saat ia sudah ada di hadapan markas BEM UI itu, ruangan tersebut tampak sepi dan
pintunya pun dalam keadaan tertutup rapat. “Saya pikir bisa ketemu temanteman, kalau undangannya sudah ada, saya ambil aja undangannya,” kata Mantan Gubernur DKI Jakarta itu. “Tapi karena sekretariat kosong, mungkin teman-teman sedang kuliah jadi saya tunggu aja,” imbuhnya. (jpc)
BOGOROrganisasi nirlaba global, Belantara Foundation kembali menggelar webinar Belantara Learning Series secara hybrid pada Rabu (30/8) di Universitas Pakuan Bogor. Pada seri ke-7 ini, Belantara Foundation mengangkat tema konservasi satwa liar orangutan.
FATUR/RADAR BOGOR
"Dalam memperjuangkan konservasi hewan liar kami tidak bisa bergerak sendirian. Oleh karena itu kami menggandeng mitra lain dari akademisi, pemerintah, penggiat lingkungan, Lembaga Swadaya Masyarakat (LSM) konservasi, dan sektor swasta," jelasnya.
Direktur Eksekutif Belantara Foundation, Dolly Priatna menjelaskan, webinar tersebut bertujuan menginformasikan soal ilmu pengetahuan, dan memberikan pelatihan terkait konservasi lingkungan, terutama metode kajian orangutan di alam.

Ia membeberkan, orangutan salah satu spesies yang hanya dimiliki Indonesia tepatnya Pulau Sumatera dan Kalimantan. Saat ini, keberadaan mereka terancam karena kebanyakan habitatnya tumpang tindih dengan dunia usaha. Dolly berharap, isu kon-
servasi satwa liar ini bukan hanya menjadi isu pegiat konservasi saja, melainkan juga menjadi isu bersama sehingga dapat men dorong gerakan bersama. "Oleh karena itu kami sosialisasikan ini pada generasi muda perkotaan supaya mereka dapat terbuka wawasannya soal ancaman hilangnya keanekaragaman hayati. Walaupun tidak mudah untuk merubah perilaku, perlu upaya terus menerus," tutur dia.
Webinar ini diikuti sebanyak 700 peserta, yang terdiri dari mahasiswa Universitas Pakuan, Universitas Nasional, Univer-
sitas Riau, Universitas Andalas, Universutas Tanjungpura, Universitas Nasional, dan Universitas Gajah Mada. Dalam kesempatan itu, hadir sejumlah narasumber dari kalangan milenial yang aktif dalam dunia konservasi alam. Di antaranya Manajer Program Forum Konservasi Orangutan Indonesia, Fajar Saputra, Representatif FHK Sumatra Utara, Tarmizi, Pengurus Bidang Riset Forum Konservasi Gajah Indonesia, Dwi Adhari Nugraha, dan Peneliti Orangutan Magister Biologi Universitas Nasional, Prima Lady. (fat/c)

Sambungan dari Hal 12
Langkah awal yang dilakukan adalah memindahkan ratusan pedagang kaki lima (PKL), yang hingga kini memenuhi jalur pedestrian di sana. Khususnya di Jalan Nyi Raja Permas. Kemarin, Satpol PP Kota Bogor pun mengundang beberapa perwakilan PKL di sana, untuk membahas rencana tersebut.
Diskusi ini dilakukan untuk membahas terkait pengosongan Jalan Nyi Raja Permas, yang akan disulap menjadi pedestrian oleh Dinas Pekerjaan Umum dan Penataan Ruang (PUPR) Kota Bogor pada tahun ini. "Sudah dikomunikasikan dengan baik, kami tampung aspirasi mereka, kami siapkan relokasi di Blok F," kata Kepala Satpol PP Kota Bogor, Agustian Syach usai menggelar diskusi
di Alun-alun Kota Bogor. Rencananya, dijelaskan pria yang kerap disapa Demak, sebanyak 240 PKL itu mulai mengosongkan lapaknya di Jalan Nyi Raja Permas mulai Rabu (30/8) kemarin. "Insya Allah hari ini (kemarin, red) sudah pindah semua masuk Blok F. Kami kasih keleluasaan waktu hari ini, kami juga ajak mereka melihat lokasi kios-kios mereka di Blok
Sambungan dari Hal 12
Informasi yang dihimpun, bocah laki-laki berusia 7 tahun ini belum diketahui keberadaannya, usai mengejar kucing.
"Kemaren sekitar jam 14.00
WIB, (Daniyal Gaisani) ngejar-ngejar kucing di sekitar rumahnya, tapi gak ke pantau sama orang tuanya," kata Ilham kepada wartawan, Rabu (30/8)
siang.
Menurut dia, keberadaan keponakannya yang saat ini bersekolah di SD Perwira Kota Bogor itu, terpantau oleh tetangga sekitar di sekitar
Taman Manunggal, Kecamatan Bogor Barat. Ilham menjelaskan, hingga kini keberadaanya belum diketahui, dan pihak keluarga juga sudah berupaya melakukan
pencarian ke berbagai tempat, di Kota Bogor. Dirinya berharap, ada warga atau siapapun yang menemukan keponakanya, untuk dapat menghubungi pihak keluarga.
"Bagi siapa saja yang mengetahui atau menemukan Daniyal Gaisani, harap menghubungi 089533728087," tukas dia.(ded/c)
Sambungan dari Hal 12
Batalnya pembongkaran lapak PKL ini, lantaran para pemilik sudah membongkar kios mereka masing-masing.
"Saya berterima kasih kepada pedagang sudah bisa memahami tugas kami disana, sehingga mereka melakukan pembongkaran sendiri kios-kios
mereka," kata Kepala Satpol PP Kota Bogor, Agustian Syach. Namun demikian, Agustian mengaku akan kembali melakukan monitoring pemantauan ke PKL di kawasan Warung Jambu. Selain itu, pihaknya akan menempatkan personel dalam waktu tertentu.
Pada kesempatan ini, pria
yang kerap disapa Demak juga berharap, agar para pemilik kios tidak kembali mendirikan lapaknya di lokasi tersebut.
"Harapannya itu, kalau sudah kosong mereka jangan balikbalik lagi," ucap dia.
"Kayanya akan ada intervensi dari Dinas Pertamanan untuk buat taman disana," tandas Demak.(ded/c)
Sambungan dari Hal 12
Kepala Unit Penegak Hukum, Satlantas Polresta Bogor Kota, IPDA Susilo menjelaskan, kecelakaan tunggal tersebut diduga terjadi karena truk itu kelebihan muatan.
"Saat menikung, sopir kurang menguasai medan, sehingga
patah as-nya lalu muatan yang dibawa tumpah ke sebelah kiri," terangnya. Truk tersebut kemudian ditangani oleh pihak kepolisian, dan diamankan ke tempat penitipan barang bukti di Ciawi, Kabupaten Bogor. Sementara itu, karung-karung
beras bulog yang tercecer di badan jalan, dievakuasi menggunakan truk lain. "Saat kejadian lalu lintas tidak sedang ramai, sehingga tetap lancar. Saat evakuasi barangnya kami lakukan rekayasa laku lintas terbatas untuk mengendalikan arud kendaraan," jelas dia. (fat/c)
F," ucap dia.
Namun demikian, Demak mengatakan, Satpol PP juga memberikan waktu hingga Senin (4/8) mendatang, agar pedagang bisa membersihkan lapaknya.
"Selasanya akan kami lakukan pemeriksaan, dan membongkar lapak-lapak yang belum dibenahi," tegas dia.
Diakui Demak, memang pada diskusi ini masih ada beberapa pedagang yang meminta tetap bisa berjualan di Jalan Nyi Raja Permas, setelah pembangunan pedestrian selesai nanti.
Akan tetapi, karena hal tersebut bukan menjadi kewenangannya, dia menyarankan ke pedagang untuk mencoba berjualan terlebih dahulu di dalam Blok F.
"Jadi mereka itu pengen, ya ini beres (pedestrian), mereka balik lagi. Kan saya bilang belum tentu di dalam juga sepi, kalau itu rame kan mereka enggak mungkin balik lagi," ungkap dia.
Kedua, penataan ini, sangat erat kaitannya dengan kebijakan pimpinan dalam hal ini Wali Kota Bogor Bima Arya.
"Mungkin kalau di Blok F sepi enggak bisa hidup dan segala macam, mungkin kami akan menyampaikan itu (ke pimpinan)," ucap Kepala Satpol PP Kota Bogor. "(Pastinya) saya bilang coba dulu, Insya Allah dengan mereka masuk semua rame. Yang pasti saya bilang jangan ada pengkhianat, sepakat ke dalam tapi malah balik lagi berjualan di jalan," sambung Demak. Ditambahkan Demak, bahwa kepindahan PKL Nyi Raja
DISKUSI: Satpol PP Kota Bogor berdiskusi dengan perwakilan PKL Nyi Raja Permas, kemarin.
Permas ke dalam Blok F Pasar Kebon Kembang ini tidak dikenakan biaya. Pengelola hanya sebatas membebani biaya service cash.
"Satu tahun kami sudah diskusi dengan pengelola Blok F, mereka membebaskan biaya sewa selama satu tahun. Nanti service cash hanya Rp100 ribu per bulan," kata dia. "Dan saya juga sudah diskusi dengan pengelola Blok F, nanti (setelah setahun) mereka akan di tawarkan opsi kepemilikan
DEDE/RADAR BOGOR

20 tahun. Dengan cicilan enggak nyampe Rp500 ribu perbulan," ujar Kepala Satpol PP Kota Bogor. Diketahui, pengosongan Jalan
Nyi Raja Permas dilakukan buntut pembangunan lanjutan trotoar Alun-alun Kota Bogor, serta pekerjaan saluran yang menuju ke Jalan MA Salmun. Di mana, kegiatan yang dimenangkan CV Maju Maju Mapan itu memiliki pagu anggaran senilai Rp6 miliar dari APBD Kota Bogor 2023. (ded/c)
Sambungan dari Hal 12
Ketua Kwartir Cabang (Kwarcab) Gerakan Pramuka sekaligus Wakil Wali Kota Bogor, Dedie A. Rachim menerima dan disematkan Lencana Dharma Bhakti oleh Gubernur Jawa Barat, Ridwan Kamil, yang juga merupakan Ketua Majelis Pembimbing Daerah (Mabida) Gerakan Pramuka Jawa Barat.
Selain disematkan lencana, Kota Bogor juga menerima penghargaan juara pertama Kwarcab Juara 2023 Kategori A dari Kwarda Jabar.
"Kota Bogor termasuk salah satu kwarcab paling aktif tergiat se-Jawa Barat, untuk itu kita diberikan penghargaan
Kwarcab Juara Kategori A. Ditambah saya mendapatkan
Lencana Dharma Bhakti. Semua anggota pramuka Kota Bogor yang hadir gembira dan tersanjung. Alhamdulillah," ungkap Dedie, usai pelaksanaan peringatan Hari Pramuka tingkat Jawa Barat. Rasa gembira juga diungkapkan Ade Sarip Hidayat. Mantan Sekretaris Daerah (Sekda) dan Ketua Kwarcab Gerakan Pramuka Kota Bogor itu juga mengungkapkan, sebagai pengurus terdahulu, hal ini menjadi suatu pencapaian yang baik. "Dulu sempat ada kekhawatiran, namun dengan semangat Kak Dedie dan yang lain, ternyata predikat tergiat itu diperoleh dan bisa dipertahankan. Saya ucapkan selamat," tambah Ade yang sekarang ini menjadi pengurus
Sambungan dari Hal 12
Masih minimnya tingkat
literasi di Kota Bogor, mendorong Dewan Kemakmuran
Masjid Al Muttaqin menggelar
Pasar Buku bertajuk Taman
Literasi, dan Edukasi Urang
Sarerea (Taleus) Bogor. Pasar buku yang digelar di area Aula masjid ini, menyediakan ribuan buku dari berbagai jenis dan genre.
Ketua Panitia Pasar Buku
Taleus Bogor Rita Saadah menerangkan, event tersebut
akan berlangsung selama 4 hari ke depan, hingga 3 September mendatang. Jenis buku yang dijajakan, antara lain novel, buku parenting, agama, cerita, non fiksi, dan masih banyak lagi. "Kami ingin memberikan ruang bagi yang ingin membeli buku dan berupaya meningkatkan literasi masyarakat sehingga lebih berminat serta serius dalam membaca dan menulis," terangnya.
Selain menyediakan ribuan buku, event ini juga menyelenggarakan sejumlah kegiatan,
seperti bedah buku, talkshow, workshop, bengkel menulis, lomba berpuisi, dan lomba story telling.
Rita menerangkan, pihaknya memberikan diskon pada setiap buku yang dijual, dalam Pasar Buku ini. Sehingga harga yang ditawarkan jauh lebih murah, dibanding harga di toko offline maupun online. Kesempatan ini pun tak disiasiakan para pecinta, dan penikmat buku. Mereka yang datang dari sejumlah daerah di Kota Bogor itu, langsung
menyerbu meja berisi tumpukan buku itu.
Tak terkecuali Wali Kota Bogor, Bima Arya. Bima bahkan memborong delapan buku sekaligus, sehingga membuat tasnya penuh dengan buku.
Menurut Bima, pasar buku menjadi cara yang baik dalam memakmurkan masjid. Ia menilai event Pasar Buku dapat menginspirasi masjid-masjid lainnya, untuk menyelenggarakan event serupa. Dirinya bahkan membuka diri lebar-lebar, untuk berkola-
borasi dan memberikan bantuan berupa penyediaan buku, dan peralatan bagi perpustakaan Masjid Al Muttaqin yang turut diresmikan pada kesempatan itu. "Membaca bukan sekadar menambah wawasan, tapi juga merupakan jendela dunia untuk membangun karakter. Baginya pembangunan manusia tak kalah penting dengan pembangunan infrastruktur fisik. Saya percaya itu bisa dilakukan lewat (membaca) buku," ujar dia. (fat/c)
Pramuka di Jawa Barat. Di tempat yang sama, Gubernur Jawa Barat, Ridwan Kamil menegaskan, semua unsur termasuk pramuka harus berbakti kepada negeri tanpa henti.
Gerakan Pramuka Jawa Barat menjadi yang terbanyak anggotanya se-Indonesia. Yakni mencapai 8 juta anggota.
"Adik-adik, hidup itu harus punya semangat yang penuh dengan visi, semangat de ngan penuh integritas dan semangat berkarya. Itu Dasa Dharma yang saya terapkan

sebagai pemimpin Jawa Barat," kata RK.
Menambahkan, Ketua Kwarda Jabar, Atalia Praratya mengatakan, Pramuka Indonesia khususnya Jawa Barat dianggap sebagai pramuka yang paling tangguh di mata nasional hingga internasional.
"Hari ini harus menjadi momentum, agar kita terus menggeliatkan semangat kemajuan kekinian dalam pengembangan gerakan pramuka di seluruh Jawa Barat," tegas Atalia.(ded/c)
MERAYAKAN HUT Ke-58, Ikatan Konsultan Pajak Indonesia (IKPI) Bogor dan Depok menggelar FUNWALK 4K di Kebun Raya Bogor pada Minggu (27/8). Perserta FUNWALK yang hadir adalah anggota IKPI Cabang Bogor dan Depok beserta keluarga. Dihadiri juga Ketua IKPI Depok, Nuryadin dan Ketua Cabang Bogor, Pino Sidharta. Setelah FUNWALK, semua peserta ikut bermain games seru. Kegiatan terakhir ada pembagian doorprize di mana hadiah yang disediakan merupakan hasil dari sumbangan seluruh peserta. (mer/c)


Pesantren Al Umm Aswaja
TERLIBAT: Para pasukan pengibar bendera merah putih dari Pesantren Al Umm Aswaja foto di kawasan Tugu Kujang usai pengibaran bendera.

Ikatan Konsultan Pajak Indonesia (IKPI) Bogor dan Depok
SESUAI jadwal pengibaran dan penurunan bendera Merah Putih di Tugu Kujang selama Agustus, dari tanggal 1-31 Agustus, melibatkan sekolah dan komunitas. Dan Senin (28/8) lalu, yang bertugas adalah giliran para paskibra dari Pesantren Al Umm Aswaja. Bahkan pesantren ini merupakan pesantren yang pertama terlibat di kegiatan tersebut. Berlatih sejak beberapa minggu lalu, namun penampilan mereka cukup memuaskan. Kegiatan ditutup pada GR di Tugu Kujang. (mer/c)


Ummi Daerah (UMDA) Bogor
UMMI Foundation, yang memberikan

layanan pendidikan pembelajaran
Al Quran dengan metode Ummi
bekerjasama dengan UMDA Bogor
dan SD Amaliyah Ciawi, mengadakan
Festival Metode Ummi (Fesmi) Bogor
Raya ke-1, Minggu (27/8).
Dengan mengangkat Tema Kuatkan
Mutu, Raih Prestasi, Pererat Silaturrahim, kegiatan ini diikuti seluruh
siswa/siswi TK, SD, SMP, TPA atau TPQ pengguna Metode Ummi SeBogor Raya di antaranya Bogor kota & Kabupaten, Cianjur dan Sukabumi. Pelombaan tersebut terdiri dari 18 jenis lomba. Yang diikuti sekitar 170 lembaga pengguna Ummi dan sekitar 700 peserta. Selain lomba, diadakan pula seminar dan talk show Qurani. (*pia)
Wanita Islam Daerah Kota Bogor

SEBAGAI salah satu komunitas, secara nasional Wanita Islam dibentuk pada tahun 1962 dan tahun ini memasuki usia 61 Tahun. Rabu (30/8) kemarin, pengurus daerah Bogor mengelar puncak perayaan tingkat Kota Bogor di Gedung GOW, Jalan
Sudirman. Selain anggota dan pengurus Wanita Islam Daerah Kota Bogor, hadir juga dari pengurus pusat dan wilayah serta penasihat.
Diketuai Citra Hartati, milad tahun ini sekaligus perayaan HUT Kemerdekaan RI ke 78 tahun.
Wanita Islam sebagai organisasi muslimah yang independen , unggul dalam pengabdian kepada umat. Dan memiliki peran stategis serta mampu mengatasi permasalahan dalam masyarakat lokal nasional dan lainlain. (mer/c)
INDEPENDEN: Para pengurus dan anggota Wanita Islam Daerah Kota Bogor saat perayaan HUT ke 61 Tahun di Gedung Wanita.

Sebuah truk pengangkut beras bulog terguling di sekitar Kawasan Tugu Kujang, pada Rabu (30/8) dini hari. Kondisi ini membuat karung-karung beras itu tumpah, dan



Wajah Kota Bogor terus dipercantik Pemerintah Kota (Pemkot) Bogor. Dalam waktu dekat, giliran kawasan Alun-Alun Kota Bogor yang bakal ditata.







SIBUK menjadi Sekretaris 1 Komisi Penanggulangan AIDS (KPA) Kota Bogor, Cyamiati Karolin tetap menyempatkan waktunya untuk berolahraga.




Senam menjadi olahraga yang paling disukainya. Manfaat yang dirasakan, membuatnya ketagihan menjalani senam.
Menurutnya, senam membuat tubuhnya lebih bugar, dan jarang sakit."Sebelum rajin senam, setiap menjalani aktivitas ada saja yang dirasakan. Bahkan harus diurut (pijat). Tapi sekarang sudah bebas dari rasa itu," ucapnya.



Tak sendirian, Cyamiati selalu senam bersama rekan-rekannya di komunitas, dan sanggar.
Menurutnya dengan bersamasama olahraga, menjadi tidak memberatkan lagi.

"Biasanya senam jantung sehat atau aerobik. Dalam seminggu bisa 3 kali. Senamnya ramairamai kalau sendirian males," tutur dia. (fat/c)

BOGORSatuan Polisi Pamong Praja (Satpol PP) Kota Bogor batal membongkar lapak Pedagang Kaki Lima (PKL) yang berada di sekitaran Warung Jambu, Kelurahan Bantarjati, Kecamatan Bogor Utara pada Rabu, (30/8).

BERSIH: Lapak PKL di kawasan Warung Jambu telah bersih dibongkar para pedagang secara mandiri.
Event Pasar


Meski baru digelar pertama kali dalam sejarah, Pasar Buku Taleus Bogor ala Dewan Kemakmuran Masjid Al Muttaqin, langsung jadi serbuan masyarakat. Bahkan Wali Kota Bogor, Bima Arya langsung memborong buku.

Laporan: REKA FATURACHMAN

KEJAR KUCING, ABK DI BOGOR
SEORANG anak berkebutuhan khusus bernama Daniyal Gaisani dilaporkan hilang, saat bermain di depan rumahnya pada, Sela sa (29/8).